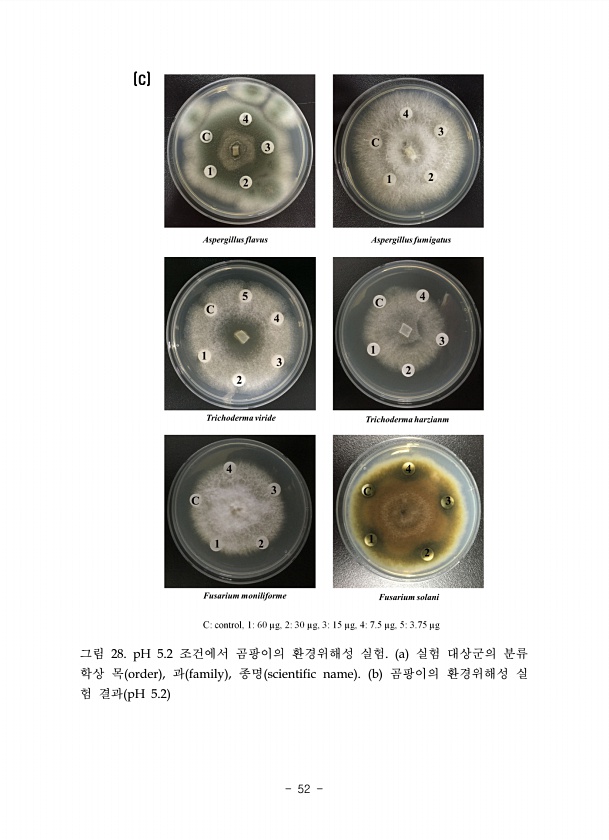

국립생태원에서 제공하는 수많은 자료를 e-Book으로 볼 수 있습니다.
통합검색
제목 : (2016) 해충저항성 LMO의 환경위해성 연구
발행일 : 2014-01-01 | 조회수 : 4266
카테고리 :
그림 28. pH 5.2 조건에서 곰팡이의 환경위해성 실험. a 실험 대상군의 분류 학상 목 order , 과 family , 종명 scientific name b 곰팡이의 환경위해성 실 험 결과 pH 5.2

제목 : 국가 생태계서비스 평가 : 국가 생태계서비스 평가 보고서 발간을 위한 기초 연구
발행일 : 2014-01-01 | 조회수 : 7570
카테고리 :
국가 생태계서비스 평가 보고서 발간을 위한 기초 연구 48 그림 Ⅱ 22. 국외 문헌 키워드 시기2의 컴포넌트1 3시기 키워드 네트워크 분석을 위해 2013년2016년 6월 발표된 논문들을 수 집하였고, 키워드는 총 9226개이다. 이 가운데 분석 키워드이자 가장 많이 도출된 Ecosystem services를 제외하고, 30번 이상 등장하는 키워드를 분석 대상에 포함 하였다 99.6%, 상위 0.5%만 분석에 포함 키워드 시기1, 2와 동일한 수준으로 분 석 cut-off를 정하려 했으나 네트워크 그림에서 노드 간 관계가 보이지 않을 정도 로 많은 키워드가 도출되었고, 적정한 시각화를 위해 cut-off를 정하였다. 이를 위 해 SPSS에서 표 Ⅱ 18 을 도출하였다. 빈도 퍼센트 올바른 퍼센트 누적 퍼센...

제목 : LMO 자연환경 모니터링 및 사후관리 연구(VII)
발행일 : 2015-01-01 | 조회수 : 8210
카테고리 :
순번 Sample NO. 순번 Sample NO. 1 Non-LM 9 NIE15-G4-1025 2 T45 10 NIE15-G4-1026 3 Ms8 11 NIE15-G4-1027 4 Rf3 12 NIE15-G4-1028 5 GT73 13 NIE15-G4-1029 6 T19-2 14 NIE15-G4-1030 7 NIE15-G4-1022 15 NIE15-G4-1031 8 NIE15-G4-1024 16 NIE15-G4-1032 그림 25. 캐놀라 음성반응 내재유전자 분석 결과-3 순번 Sample NO. 순번 Sample NO. 1 Non-LM 9 NIE15-G6-1047 2 T45 10 NIE15-G6-1048 3 Ms8 11 NIE15-G6-1050 4 Rf3 12 NIE15-G6-1051 5 GT73 14 N...

제목 : 담수생태계, 기후변화와 환경교란 : 강과 습지는 어떻게 바뀔까?
발행일 : 2014-01-01 | 조회수 : 7008
카테고리 :
담수생태계, 기후변화와 환경교란 67 저서성대형무척추 동물의 주요 먹이 섭식 섭식 기능군 특 징 썰어먹는 무리 shredder 낙엽 등과 같은 굵은 유기입자를 섭식하는 무리 굵은 유기입자를 찢기 위한 입 구조를 가짐 모아먹는 무리 collector 주워먹는 무리 collector-gatherer 하류로 떠내려 오는 작은 유기입자를 섭식하는 무리 주로 하상에 퇴적된 유기입자를 섭취함 걸러먹는 무리 collector-filterer 하류로 떠내려 오는 작은 유기입자를 섭취하는 무리 긁어먹는 무리 grazer, scraper 하상에 붙어있는 부착조류를 긁어서 섭식하는 무리 잡아먹는 무리 predator 다른 동물을 잡아먹는 무리 전반적으로 유속이 빠르고 큰 바위를 중심으로 한 하상구조가 형성된 하천 상류에서는 빠...

제목 : 자연환경보전사업 설계 가이드라인
발행일 : 2015-01-01 | 조회수 : 16369
카테고리 :
60 국립생태원 자연환경보전사업 설계 가이드라인 대체서식지 조성 후보지에 대한 대안별 장단점 비교검토를 통해 적정한 입지를 결정한다. ③ 규모 서식지의 크기 및 규모는 정량적, 정성적 생물분류별 적정 규모가 확보되어야 한다. 생물종의 먹이공급이 가능한 채식공간과 은신처가 확보될 수 있어야 하며 생물종 간의 비간섭거리와 임계거리가 확보되어야 한다. 규모가 작아 거리 확보가 불가능할 경우 차단시설 및 차폐를 위한 수림대를 조성하여 장벽효과를 유도할 수 있도록 한다. ④ 구성 비율 서식환경별 구성 비율은 생물종의 특성, 물리적 자원, 환경요인에 따라 결정하며 종간 경쟁, 공생과 기생, 포식과 피식 등 상호관계를 고려한다. 생물 서식공간을 핵심공간으로 구획하며 그 외 지역은 완충, 전이구역으로 구분하여 비율을 결정...